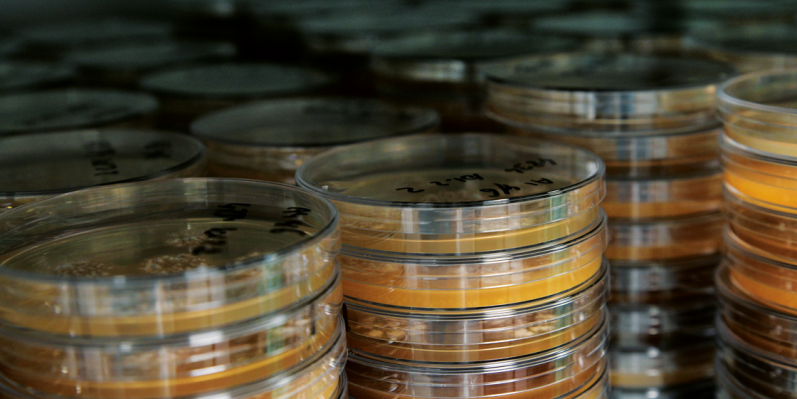
Expertise1

EXPERTISES

SOLID STATE FERMENTATION

Substrate control has played a major role to achieve our strain differentiation process.
Along the spawn process, mycelium is grown on compost, wood, peat and grain. Consistency may be reached mostly by free water monitoring.
This physical measurement is essential because of the nature itself of our hybrids. These become stronger if their water supply is accurate. Free water control of our subcultures is in essence our everyday challenge to achieve our ultimate target that is to upgrade mid-range hybrids.
To our knowledge, EuroMycel is the only spawn laboratory around the world to focus so much in that area.
Our advanced expertise also brought up the statement that rye may be the best of all available spawn substrate to carry the absorption capacity built up by the spawn process to compost; compared to millet or sorgho, it is possible to bring rye, after sterilisation, to higher level of free water combined with a low evaporation regime.
Water becomes available to fill the growing net within 12 days of growth at 25°C.


QUALITY CONTROL
Our QC laboratory is settled in the heart of our commercial facility. We do believe that consistent spawn can only be obtained by the control both of the commercial substrate and of the inoculum.
Our young team is made of various fields of expertise including genetic, mycology, bacteriology, biochemistry and soil science.

PRODUCTION EQUIPMENT
EuroMycel did not retain the option of an in line system on purpose to keep possible all kinds of adjustments required, for instance by some grain evolution: cooking and sterilisation being completely independent steps, grain conditioning can be adjusted according to free water targets without constraints of flowability.
It gives us all latitudes to put ahead mycelium expectations in terms of selectivity. Mineral powder formulations are introduced in a dry way for a perfect control of the redox potential of the substrate.
Most of our process equipment is pharmaceutical and hospital graded, flexible enough to fit perfectly with our next projects of growth.

TRACEABILITY
Each single commercial bag is identified by a commercial batch reference.
Our Quality Assurance Database is able to trace out of the code informations related to the substrate production but also to the genealogy of the commercial line.

PREDICTIVE MUSHROOM MICROBIOLOGY

A ten years research project allows EuroMycel to offer to its key customers a unique opportunity to upgrade spawn/compost interactions. Relying on EuroMycel expertise to predict water flow through the mushroom system, Strong Mushroom Spawn concept is an analytical tool aiming at customizing our commercial lines in order to meet the best growers expectations.
As mentioned earlier, the capacities of Agaricus bisporus to evolve in very short delay are endless. These powerful properties shared by most thallophytes in response to environmental changes are mostly related to sophisticated physiological regulation systems. Their strengths are that these mechanisms are quick to switch on in the labculture, as long as the strain process is properly handled till the commercial product. We therefore believe that there is always an efficient physiological response of our Agaricus bisporus spawn to all kinds of compost (i.e 'microbial infallibility theory').
Our Predictive Mushroom Microbiology system estimates how compost Water Potential (Ψ-c) matches with the whole EuroMycel strains brand Water Potential (Ψ-µ). If probabilities of success are too narrow, EuroMycel may establish some corrective actions pointing out compost Ψ gaps until Ψ-c matches with Ψ-µ.
The Strong Mushroom Spawn concept is indeed the unique predictive tool to connect your compost with success!